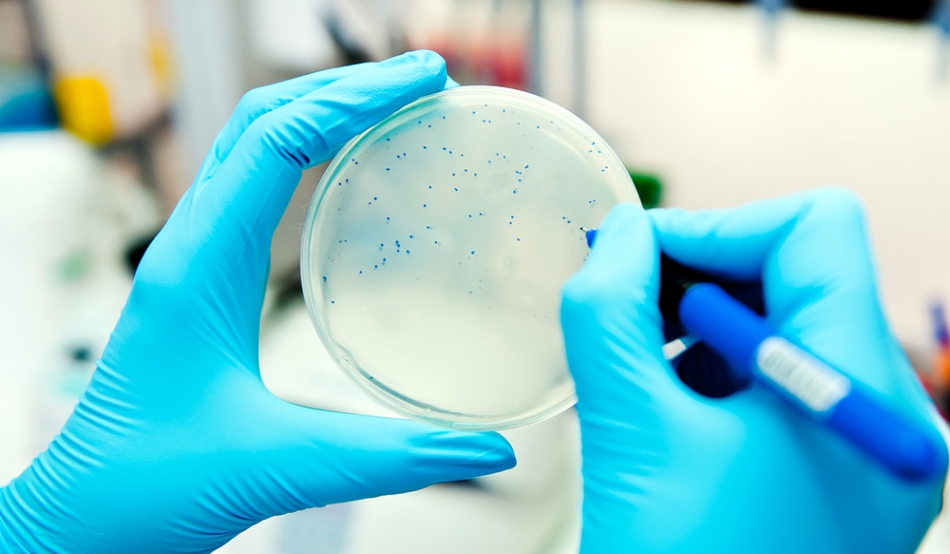

Ultimul medicament a eşuat. Bacteriile au ajuns la o genă care le permite să reziste la polimixină, antibioticul de ultimă generaţie pentru diverse tipuri de infecţie. Aceste bacterii au fost găsite în Danemarca şi China, iar acest fapt i-a determinat pe cerectători să o căutare la nivel mondial.
Descoperirea arată că bacteriile gram-negative, cele care provoacă infecţii intestinale, infecţii urinare şi sanguine la om, pot deveni acum „pan-rezistente” (rezistent la orice tratament ). Acestea vor face unele infecţii incurabile, cu excepţia cazului în care noi tipuri de antibiotice vor fi aduse pe piaţă în curând.
Colistina, cea mai frecventă polimixină, este un tratament de ultimă generaţie pentru infecţii cu bacterii, precum E. coli şi Klebsiella care rezista la toate celelalte antibiotice disponibile.
În noiembrie, Yi-Yun Liu de la Universitatea Agricolă din China de Sud, din Guangzhou, şi colegii săi au descoperit o genă rezistentă la colistină la animale infectate, carne şi oamenii. Gena mcr-1 poate migra cu uşurinţă între bacterii, iar cercetatorii au prezis că acest lucru s-ar putea extinde, în curând, la nivel mondial.
După anunţul făcut, Frank Aarestrup, de la Universitatea Tehnică Daneză din Lyngbya, început imediat să caute această secvenţă în baza de date daneză a ADN-urilor bacteriene prelevate de la oameni, animale şi alimente. El a găsit această genă la o singură persoană, care a avut o infecţie de sânge la începutul acestui an. Totodată, a mai fost găsită în cinci probe bacteriene din carnea de pasăre importată din Germania între anii 2012 şi 2014.
Genele găsite în Danemarca şi China sunt identice, afirmă Aarestrup, sugerând că gena mcr-1 a călătorit destul de mult. Se crede că a aparut iniţial la animalele de la ferme hrănite cu colistină ca un stimulent de creştere antibiotic.
„Noi nu ştim de unde provine această genă”, avertizează Frank Aarestrup. Echipa lui încearcă să afle originile ei prin colectare informaţiilor, prin intermediul proiectelor de cercetare la nivel mondial şi cele ale Uniunii Europene existente deja, care compilează secvenţe genetice de la agenţi patogeni.
O origine potenţială poate fi China, fiindcă antibioticele sunt pe larg folosite în hrana animalelor pentru a le stimula creşterea. Cea mai mare parte din cele 12.000 de tone de colistină utilizate, anual, în hrana pentru animale este folosită în China, afirmă Yi-Yun Liu şi colegii săi. Ei consideră că colistina favorizează evoluţia mcr-1. Stimularea creşterii animalelor pe bază de antibiotice a fost interzisă în Europa, tocmai pentru că favorizează dezvoltarea bacteriilor rezistente la medicamente. În mod ironic, Danemarca a fost printre primii care le-au interzis.
Medicamentele sunt încă pe larg utilizate pentru tratamentul infecţiilor comune, precum diareea, în hambarele aglomerate cu animale. În 2012, Organizaţia Mondială a Sănătăţii a numit colistina foarte importantă pentru sănătatea umană, ceea ce înseamnă că utilizarea sa în raport cu animelele ar trebui să fie limitată pentru a evita promovarea rezistenţei. Totuşi, în 2013, Agenţia Europeană pentru Medicamente a raportat că polimixina era al cincilea cel mai des folosit antibiotic, în efectivele europene de animale.
„Colistina este folosită în India şi la oameni şi la animale. Am tratat infecţii rezistente la colistină, dar şi cercetători din India au de gând să testeze probele bacteriene pentru această genă”, afirmă Abdul Ghafur reprezentantul Spitalului Apollo din Chennai.
India este un alt focar de rezistenţă la antibiotice din cauza controalelor slabe a medicamentelor. „Dacă mcr-1 este prezent în India atunci va fi un dezastru”, afirmă Ghafur, care se teme că această genă se va răspândi rapid la fel ca în cazul genei rezistente la un alt antibiotic, carbapenem.